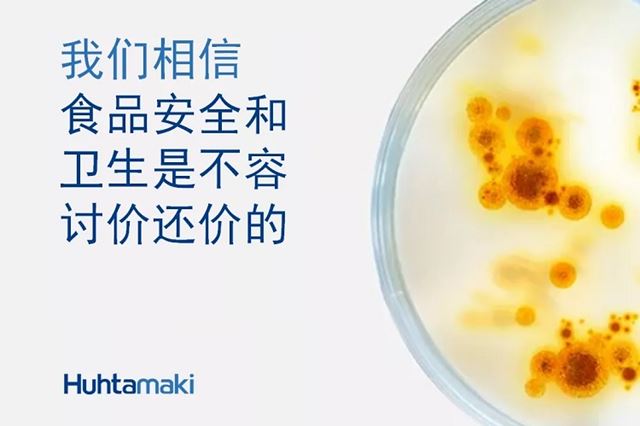

虽然食物包装出现的契机平常,但在促进食品卫生和安全方面、以及在现代社会的发展和进步中发挥了重要的支持作用。全球社会的复杂性和相互关联性进一步凸显了通过适合的包装来实现、能够应对意外挑战的弹性供应链的必要性。事实上,在提高食品价值链的效率方面,联合国粮食及农业组织强调了政策的连贯性及在食品包装方面投资的重要性。
食品包装确保了食品卫生和安全,在推动全民获得食物方面起到了关键作用
世界卫生组织(WHO)估计全球每年有2300万食源性疾病病例,食品安全机构和当局早就发现导致食源性疾病的最常见原因是交叉感染;这就是在人类食物链的各个不同阶段投入大量资源来预防食物交叉感染的原因。
食品包装在预防这种交叉感染方面作用明显。例如,人类为了减少交叉污染和降低食源性疾病的发生率而发明了现代纸杯。19世纪下半叶,水成为酒的健康替代品,喝水在美国越来越受欢迎。虽然喝到水很容易,但是用于饮水的共用杯易于传播疾病,这对公众健康构成了威胁。为了应对这一威胁,1907年,律师兼发明家Lawrence Luellen用纸制作了一个两件套的一次性杯,而现代公共卫生的奠基人之一Samuel Crumbine博士则发起了反对使用公用水杯来对抗肺结核的运动。而新冠肺炎疫情进一步表明,应在可持续食品体系建设方面充分考虑食品包装的卫生因素。
最近,欧盟部长理事会在提交给即将召开的联合国粮食系统首脑会议审议的50项优先事项中指出,确保消费者的食品安全至关重要。因为合适的食品包装可以使食品免受化学、生物和物理影响,以及延缓食品变质和延长保质期,所以包装对实现食品安全非常重要。
2020年,受新冠肺炎疫情的影响,7.2亿至8.11亿人面临饥饿的威胁,同比增加了1.2亿人。在更广泛的食品供应链上,新冠肺炎疫情的更大影响源自需求的突然变化及其对从农场到餐桌中间各个环节的破坏性影响。对消费者来说,由于新冠肺炎疫情而失去工作和生计产生的复合效应,又增加了粮食安全的风险。欧洲卫生和食品安全专员Stella Kyriakides在世界食品安全日的演讲中深刻指出面临的这一困境:
"新冠肺炎疫情不仅凸显了强有力的卫生危机准备和预防机制以及确保基本商品持续流动的供应链的重要性,还凸显了民众获得能够负担得起的安全食物的至关重要性。安全且营养丰富的食物增强人体免疫力,使我们远离疾病。安全的食物是食品安全议题的关键。"
食品包装的好处还不止健康和安全,它还以从前难以想象的方式支持着现代生活。从上世纪50年代起,因为专业人士、上班族和学生等往往时间紧迫,快餐就成为许多现代家庭的选择。最近,记者Emily Matchar调查了食品包装使人们获得能够负担得起的即食且健康食品而带来的经济和社会影响。20世纪这一现象主要出现在欧洲和北美,而今,随着城市化步伐的加快和劳动力均等化程度的提高,外卖和即食食品的需求也在不断增加,这一趋势正在迅速迈向全球。
弹性食品包装价值链有助于解决城市化加剧带来的问题
目前,全球56%的人口居住在城市地区,而20世纪初这一比例还不到15%。在运输和分销食品的过程中,食品包装的作用更加明显。即使在相对稳定的时期,不断增长的城市人口对于提供必要食物和供给的要求越来越复杂,但展望未来,维持食品包装价值链,使其在面对意外气候或其他挑战时具有弹性,对于支持生活和生计以及实现卫生、安全和人们负担得起的食品供应是至关重要的。
正是由于这个原因,在新冠肺炎疫情期间,世界各国政府将包装行业视为重要的基础行业。欧洲环境署认为,除了确保市场供应外,如果没有合适的包装,在新冠肺炎疫情下,咖啡馆和餐馆很难提供外卖食品。
我们对可持续未来的承诺
获得营养、安全和健康的食物是生活中不可或缺的组成部分。然而,目前全球9%的人口却无法获得足够的食物。欧盟部长理事会强调,联合国粮食系统首脑会议应鼓励采取有效措施,通过可持续的食物体系,让所有人(即便是弱势群体也不应被排除在外)都能够获得负担得起的健康食品。合理的食品包装有助于加强食物体系运作,既可以提高人们获得负担得起的安全食品,又可以减少食品损失和浪费。
最终,安全的食品是保证身体健康的前提。食品安全关乎社会、经济发展甚至整个人类的发展。食品包装是实现所有人每天都可以获得健康安全食物的重要条件。我们相信获得安全的食品是每个人的权利。